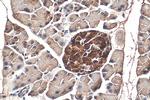
SERPINI2 Antibody in Immunohistochemistry (Paraffin) (IHC (P))

Search
Proteintech
SERPINI2 Polyclonal Antibody
{{$productOrderCtrl.translations['antibody.pdp.commerceCard.promotion.promotions']}}
{{$productOrderCtrl.translations['antibody.pdp.commerceCard.promotion.viewpromo']}}
{{$productOrderCtrl.translations['antibody.pdp.commerceCard.promotion.promocode']}}: {{promo.promoCode}} {{promo.promoTitle}} {{promo.promoDescription}}. {{$productOrderCtrl.translations['antibody.pdp.commerceCard.promotion.learnmore']}}
产品信息
13298-1-AP
种属反应
宿主/亚型
分类
类型
抗原
偶联物
形式
浓度
规格
纯化类型
保存液
内含物
保存条件
运输条件
产品详细信息
Immunogen sequence: LEMVQLGAK GKAQQQIRQT LKQQETSAGE EFFVLKSFFS AISEKKQEFT FNLANALYLQ EGFTVKEQYL HGNKEFFQSA IKLVDFQDAK ACAEMISTWV ERKTDGKIKD MFSGEEFGPL TRLVLVNAIY FKGDWKQKFR KEDTQLINFT KKNGSTVKIP MMKALLRTKY GYFSESSLNY QVLELSYKGD EFSLIIILPA EGMDIEEVEK LITAQQILKW LSEMQEEEVE ISLPRFKVEQ KVDFKDVLYS LNITEIFSGG CDLSGITDSS EVYVSQVTQK VFFEINEDGS EAATSTGIHI PVIMSLAQSQ FIANHPFLFI MKHNPTESIL FMGRVTNPDT QEIKGRDLDS L (66-415 aa encoded by BC027859)
靶标信息
The protein encoded by this gene is a member of the serine protease inhibitor superfamily made up of proteins which play central roles in the regulation of a wide variety of physiological processes, including coagulation, fibrinolysis, development, malignancy and inflammation. The gene product may have a role in a growth-control, possibly growth-suppressing pathway and, when impaired, may be involved in pancreatic carcinogenesis. The protein is a member of the plasminogen activator inhibitor-1 family, a subset of the serpin superfamily whose members act as tissue-specific tPA inhibitors. Two alternatively spliced transcript variants encoding distinct protein isoforms have been found for this gene.
仅用于科研。不用于诊断过程。未经明确授权不得转售。
篇参考文献 (0)
生物信息学
蛋白别名: Myoepithelium-derived serine protease inhibitor; myoepithelium-derived serine proteinase inhibitor; neuroserpin; Pancpin; Pancreas-specific protein TSA2004; pancreas-specific serpin; Peptidase inhibitor 14; PI-14; protease inhibitor 14; serine (or cysteine) peptidase inhibitor, clade I, member 2; serine (or cysteine) proteinase inhibitor, clade I (neuroserpin), member 2; serine (or cysteine) proteinase inhibitor, clade I (pancpin), member 2; Serine protease inhibitor 14; Serpin I2; serpin peptidase inhibitor, clade I (pancpin), member 2; serpin peptidase inhibitor, clade I, member 2; SERPIN12; TSA2004; unnamed protein product
基因别名: MEPI; PANCPIN; PI14; SERPINI2; Spi14; TSA2004
UniProt ID: (Human) O75830, (Mouse) Q9JK88
Entrez Gene ID: (Human) 5276, (Rat) 171149, (Mouse) 67931